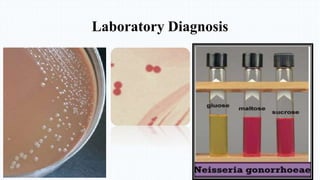
Laboratory Diagnosis

Gram-negative cocci Neisseria gonorrhoeae and Neisseria meningitidis are pathogenic to humans. N. gonorrhoeae causes gonorrhea, primarily infecting the genitourinary tract and sometimes disseminating. Left untreated, it can cause pelvic inflammatory disease, ectopic pregnancy, and sterility in women. N. meningitidis is a leading cause of bacterial meningitis and can cause septicemia. Both are diagnosed through culture and biochemical testing of clinical samples and treated primarily with cephalosporins or penicillin.